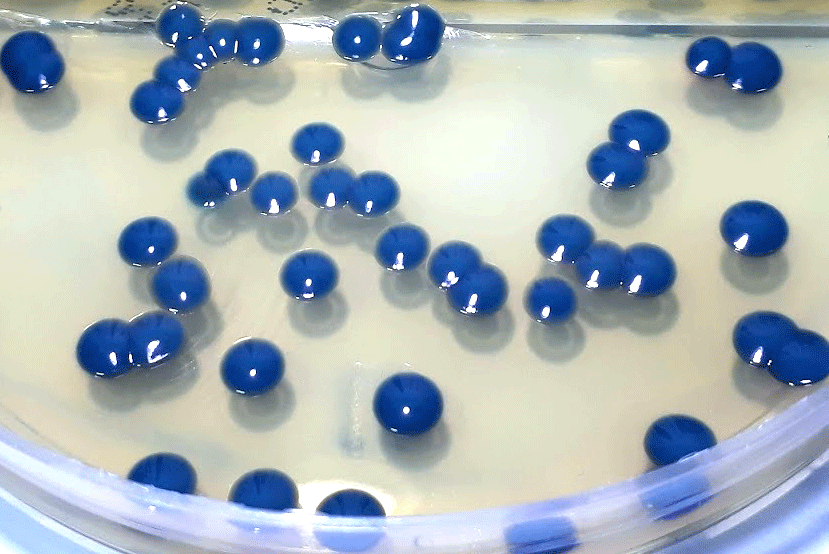
Imagem 1
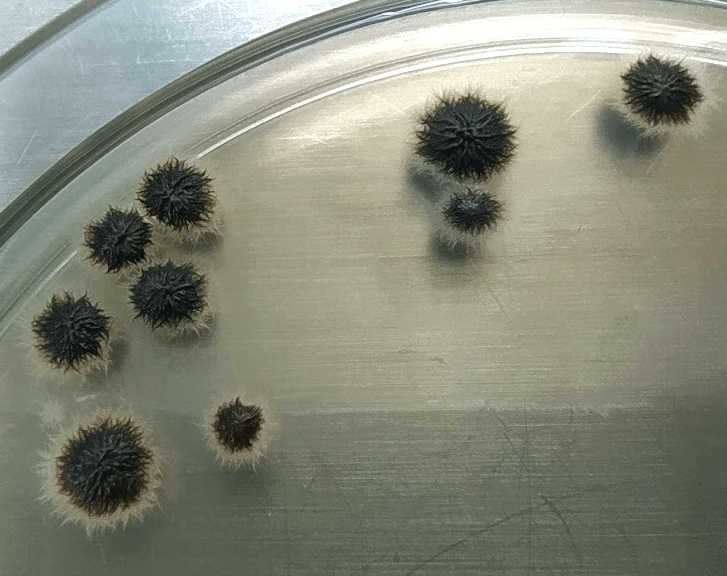
Imagem 2
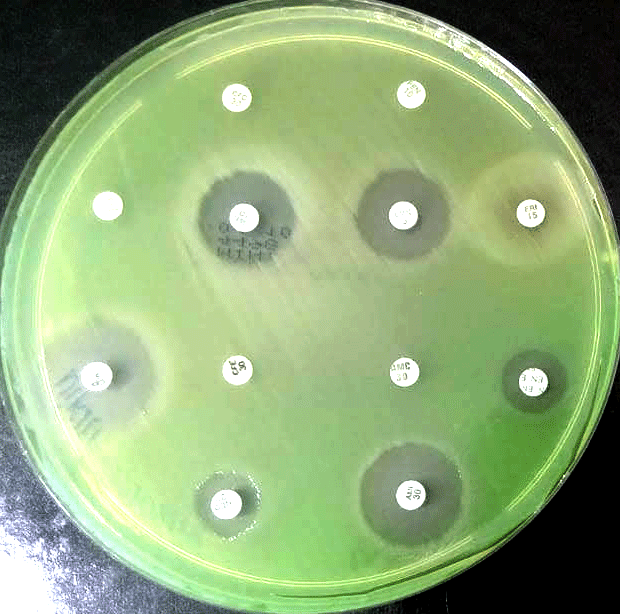
Imagem 1

Atualmente, vivemos uma epidemia silenciosa e que não para de avançar, chamada Resistência Antimicrobiana. Essa pandemia atinge as pessoas, os animais e os ecossistemas; e será uma das principais causas de morte em todo mundo nos próximos anos.
O uso indiscriminado e irresponsável dos antimicrobianos, seja na medicina humana ou veterinária, leva a um processo de “seleção bacteriana”. Assim, ao contrário do tratamento da infecção, ocorre o “fortalecimento” das bactérias não “sensíveis” aos medicamentos, que se tornam mais "resistentes" e permanecem se multiplicando, agravando a doença.
Por isso, é de extrema importância CONHECER PARA TRATAR.
As doenças infecciosas em pets fazem parte da rotina na clínica veterinária sob diversas formas, como otites, infecções do trato geniturinário, infecções da pele, infecções oculares, entre outras.
Essas alterações podem ser ocasionadas por diversos fatores, incluindo bactérias e fungos. Para chegar a um tratamento efetivo, é necessário o diagnóstico preciso.

A cultura microbiológica desempenha essa função: identificar o patógeno e orientar a terapia antimicrobiana.
O cultivo bacteriano com antibiograma e o fúngico com antifungigrama auxiliam o clínico a adotar uma terapêutica antimicrobiana guiada que trará maior chance de tratamentos bem sucedidos, resultando em maior confiabilidade ao trabalho do médico veterinário e redução eficiente do desconforto animal.
Os laudos da MicrocultVET, ajudam o veterinário a escolher a melhor terapia, de acordo com os dados encontrados “ in vitro”.
Dessa maneira, o veterinário além de acertar “no alvo” em sua terapia, favorecendo com mais rapidez a remissão da infecção e ainda contribui com minimização dos impactos da resistência antimicrobiana mundial.
Pense nisso e conte com os serviços da MicrocultVET: microbiologia veterinária a serviço da saúde única!